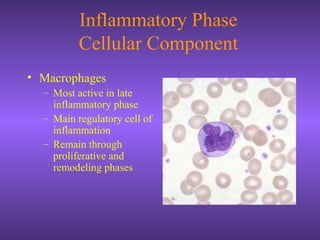
Inflammatory Phase
Cellular Component
• Macrophages
– Most active in late
inflammatory phase
– Main regulatory cell of
inflammation
– Remain through
proliferative and
remodeling phases

The document discusses wound treatment and classification. It describes the stages of wound healing as inflammation, proliferation, and formation/reorganization of scar tissue. Wounds are classified based on characteristics, depth, penetrability, infection level, and cause. Common types include incised, puncture, laceration, abrasion, and crush wounds. The document also outlines the history of wound treatment from ancient times to modern advances in closure techniques.